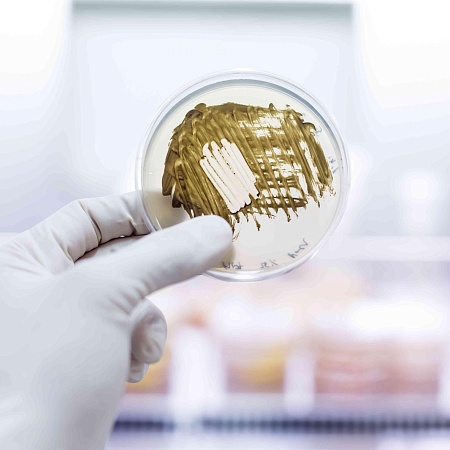

Объем программы: 36 ак.ч.
Режим занятий: не более 8 ак.ч. в день, не более 6 дней в неделю
Общая продолжительность программы: 6 дней, 1 неделя
Форма обучения: заочная
|
п/п |
Наименование модулей |
Объем, ак.ч. |
Лекция |
Самост работа (в т.ч консультации) |
Формируемые компетенции |
Форма контроля |
|
1 |
Принципы организации лабораторной службы. Первичная обработка биологического материала |
5 |
3 |
2 |
ПК-1
|
|
|
2 |
Микробиологическая диагностика гнойно-септических инфекций |
8 |
7 |
1 |
ПК-1
|
|
|
3 |
Микробиологическая диагностика инфекций, передающихся половым путем |
8 |
7 |
1 |
ПК-1
|
|
|
4 |
Методы определения чувствительности к антимикробным препаратам |
7 |
6 |
1 |
ПК-1
|
|
|
5 |
Методы лабораторной диагностики инвазивных и поверхностных микозов |
7 |
6 |
1 |
ПК-1
|
|
|
Итоговая аттестация (итоговое тестирование) |
1 |
- |
1 |
|
Тестирование |
|
|
ИТОГО |
36 |
29 |
7 |
|
|
|